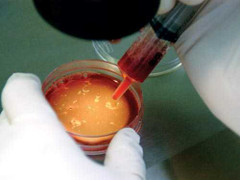
Phát hiện mới: Tinh trùng mê mẩn kim cương

Chuyện lạ: Người phụ nữ có 2 âm đạo, 2 tử cung vẫn mang thai
Krista Schwab, người phụ nữ có 2 tử cung, 2 âm chia sẻ, cô đã tưởng rằng, mình không bao giờ có thể có con, tuy nhiên, phép màu tuyệt vời đã đến với vợ chồng cô.

Krista Schwab, người phụ nữ có 2 tử cung, 2 âm chia sẻ, cô đã tưởng rằng, mình không bao giờ có thể có con, tuy nhiên, phép màu tuyệt vời đã đến với vợ chồng cô.

Không sinh được con, bà Hòa đành chấp nhận nuốt nước mắt vào trong, mang sính lễ đi hỏi vợ mới cho chồng.

Mỗi ngày, Bệnh viện Nam học và Hiếm muộn Hà Nội tiếp đón hàng trăm bệnh nhân tới khám và điều trị, đa phần trong đó tới để khám bệnh về nam khoa, với tâm lý xấu hổ, ngại ngùng…

Theo y học cổ truyền, phụ nữ hiếm muộn phần nhiều do kinh nguyệt, khí huyết không điều hòa; tuy nhiên, ẩm thực trị bệnh là một phương pháp được nhiều chị em quan tâm.

Vợ chồng nào cũng mong chờ tình yêu của mình “đơm hoa, kết trái” nhưng nhiều cặp đôi hiếm muộn do chất lượng tinh trùng của ông xã...

Trước đây, các trường hợp phát hiện tinh trùng bất động hoàn toàn thường được khuyên xin “con giống”, nhưng nay, nhờ kỹ thuật hiện đại, các bác sĩ sẽ “bắt” được những con tinh trùng sống để đặt phôi, thụ tinh ống nghiệm, giúp những nam giới mắc bệnh lý này vẫn có thể được làm bố.

Ngày 6/11/2016 vừa qua, Bệnh viện đa khoa tỉnh Phú Thọ đã đón em bé đầu tiên ra đời bằng phương pháp thụ tinh nhân tạo.

Một người đàn ông tại Mỹ cho biết mình đã có khoảng 100 người con trong vòng 4 năm qua nhờ hiến tinh trùng qua facebook.

Nhiều phụ nữ vô sinh, hiếm muộn khi tìm đến nhà thờ Đan Viện Thiên Phước cầu nguyện, xin chúa được có con thì sau đó đều “có bầu” nhưng nhiều năm vẫn không đẻ.

Mong ước được làm cha,làm mẹ của những cặp vợ chồng hiếm muộn, những giọt nước mắt là điều dễ thấy nhất. Họ khóc vì vui sướng nhưng có khi khóc vì sự tuyệt vọng

Trong hàng triệu tinh trùng chết như ngả rạ, các bác sĩ phải căng mắt rình từng con, chỉ cần hơi động đậy là bắt ngay.

Thụ tinh ống nghiệm hiện là phương pháp tối ưu nhất được chỉ định cho các cặp vợ chồng hiếm muộn.

Các nhà khoa học công bố, một loại chất mới tìm được có thể giúp tinh trùng mạnh hơn đến 70%, giúp các cặp vợ chồng hiếm muộn có thêm hi vọng sinh con.

Cặp vợ chồng lấy nhau đã 8 năm nhưng hiếm muộn cứ quấn quýt bên cháu bé bị bỏ rơi, thiết tha được nhận nuôi…

Tình trạng nam giới vô sinh hiện nay rất nhiều, sau đây xin giới thiệu bài thuốc trị vô sinh của Lương y Vũ Quốc Trung rất hiệu quả.

Tỉ lệ các cặp vợ chồng hiếm muộn ngày càng gia tăng tại Việt Nam. Đâu là nguyên nhân và hướng điều trị tích cực, hãy nghe bác sĩ chuyên khoa tư vấn.

Khả năng sinh đẻ ở nữ giới sau tuổi 40 là rất thấp, có nguy cơ gặp nhiều rủi ro tuy nhiên 11 trường hợp sinh muộn sau đây thực sự là phi thường và hiếm gặp.

Thụ thai vào thời điểm ban đêm, phòng tối giúp thụ thai tốt nhất.

Ở Việt Nam có khoảng 10% dân số bị vô sinh trong đó 60% là do nam và 40 do nữ, tuy nhiên tỷ lệ này có thể giảm xuống bởi phụ nữ thì có thể phòng ngừa vô sinh.

''Đây là niềm vui tột cùng của cả gia đình và họ hàng sau bao nhiêu năm mong đợi. Tên của cháu là Thiên Phúc với ý nghĩa phúc phận trời cho...''

Điều trị vô sinh ở Việt Nam với kỹ thuật phức tạp nhất đang tạo được uy tín trên thế giới.

(VTC News) - Rất nhiều cặp vợ chồng đã lựa chọn ra nước ngoài để chữa trị hiếm muộn.

Sau khi đã trải qua các phương pháp điều trị vô sinh hiếm muộn, nhiều cặp vợ chồng vẫn không thể có con, vì thế phải tìm đến phường án thuê người mang thai hộ.

Những đồ vật gần gũi tưởng chừng như vô hại đôi khi lại chính là nguyên nhân khiến bạn khó thụ thai, thậm chí có thể bị hiếm muộn, vô sinh.

Cao lớn, khỏe mạnh, thông minh nhưng lại không có “con giống” là tình trạng phổ biến ở vô sinh nam.

(VTC News) – Khi 2 cháu sinh ra, chúng tôi vẫn chưa thở phào nhẹ nhõm được mà chỉ đến khi có kết quả xét nghiệm ADN niềm vui mới trọn vẹn.

Theo quan điểm phong thủy, việc vô sinh hoặc khó thụ thai một phần có thể do năng lượng phong thủy đã bị khóa hoặc ngưng đọng.

Ở vùng đất sâu hút của huyện miền núi Mai Châu (Hòa Bình), người dân vẫn nhắc đến một ông lang người Thái có thể chữa hiếm muộn kỳ tài.
Phát hiện mới của các nhà khoa học Đức mở ra hy vọng mới về tỉ lệ thụ tinh.

(VTC News) - Kỉ lục mới nhất về trứng đông lạnh đã được xác lập: đó là việc ra đời của một cặp sinh đôi từ trứng đã được làm lạnh cách đây 12 năm.